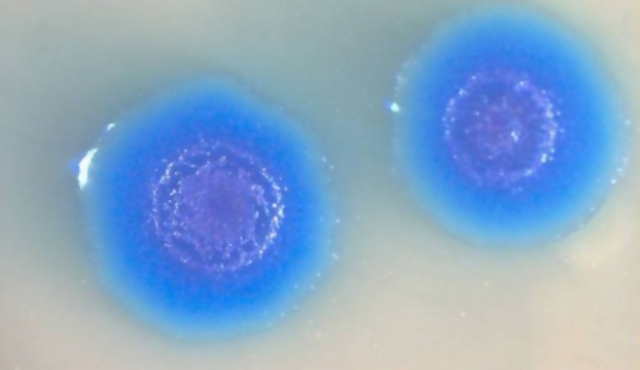
Genoma Sintético

-
Publica sus experimentos con plantas híbridas, y llama a los resultados de su investigación “Leyes de la herencia”, por lo que se le considera el padre de la genética. Estos experimentos le permitieron deducir que las características del organismo están determinadas por un par de factores, aportados por cada progenitor.
-
Aisló los núcleos a partir de células presentes en pus de vendajes quirúrgicos, y comprobó que los núcleos contenían una sustancia química homogénea y no proteica a la que denominó nucleína. Le llamó Nucleína porque estaba presente en el Núcleo, y presentaba una característica especial (tenía Fósforo, algo que era inusual en una proteína)
-
Hoppe-Seyler, inseguro con el hallazgo de Miescher decidió replicar los experimentos a lo largo de 1870. En 1871 empleó por primera vez el término «hematoporfirina» para denominar a la sustancia púrpura que logró aislar después de tratar muestras de hemoglobina con ácido sulfúrico
-
Kühne propone que se llame "enzima" a los catalizadores orgánicos que existen fuera de la célula.
-
Inició con los estudios del origen de la variabilidad, hizo varias experimentos de cruces con palomas y plantas; reconoció algunas variantes, las que después fueron denominadas como continuas y discontinuas y que a menudo se transmitían sin cambio a través de numerosas generaciones. Concluyó que la hibridación tiene un efecto unificador y un aumento en el vigor resultante de los cruzamientos. Creyó que las condiciones afectaban la variabilidad y la herencia
-
Flemming descubre la cromatina por medio de las técnicas de tinción
-
Hugo de Vries logró el redescubrimiento de las teorías de Mendel, gracias a las cuales realizó importantes estudios sobre la anatomía y fisiología de los vegetales, prestando especial atención a los mecanismos de la herencia y a la interpretación mecanística del fenómeno evolutivo de la mutación.
-
Kossel demostró que la nucleína de Miescher contenía proteínas y moléculas básicas ricas en nitrógeno, lo que llevó a la identificación de lo que hoy se conoce como bases nitrogenadas. También demostró la presencia de un glúcido de cinco átomos de carbono
-
August Weismann, formuló la teoría que afirma que el plasma germinativo es la sustancia alrededor de la cual se desarrollan las nuevas células, establecen una fundamental continuidad que no se interrumpe a través de las generaciones.En sus experimentos con ratones de laboratorio demostró que los caracteres adquiridos no se heredan.
-
Se inauguró definitivamente el Proyecto de Genoma Humano (PGH) y se calcularon 15 años de trabajo.
-
Desarrollada independientemente por Theodor Boveri y Walter Sutton. Esta teoría plantea que los alelos mendelianos están localizados en 3 partes
-
Empieza a usar Drosophila en experimentos de genetica. Gracias a su trabajo, Drosophila melanogaster se convirtió en uno de los principales organismos modelo en Genética.
-
Se reconoció la presencia de los cromosomas sexuales y de lo que se conoce en genética como “herencia ligada al sexo”. Demostró que los factores mendelianos (los genes) se disponían de forma lineal sobre los cromosomas. Morgan continuó sus experimentos y se demostró en su "Teoría de los genes" que los genes se encuentran juntos en diferentes grupos de emparejamiento, y que los alelos se intercambian o entrecruzan dentro del mismo grupo.
-
Descubrió una mosca mutante de ojos blancos entre individuos de estirpe silvestre de ojos rojos. La progenie del cruzamiento de un macho de ojos blancos con una hembra de ojos rojos presentó ojos rojos, lo que indicaba que el caracter “ojos blancos” era recesivo
-
Caracterizó las diferentes formas de ácidos nucleicos, ADN de ARN, y encontró que el ADN contenía adenina, guanina, timina, citosina, desoxirribosa, y un grupo fosfato
-
Calvin Bridges demostró que los genes están en los cromosomas; asimismo, Alfred Henry Sturtevant (como Bridges, alumno de Morgan), demostró que algunos genes tienden a heredarse juntos y dedujo que se localizan en el mismo cromosoma.
-
Se le atribuye el descubrimiento de los bacteriófagos (virus que sólo atacan y destruyen bacterias)
-
En 1915 quedaron definitivamente establecidas las bases fundamentales de la herencia fenotípica y se publicó el libro El mecanismo de la herencia mendeliana, escrito por Thomas H. Morgan, Alfred Sturtevant, Hermann Muller y Calvin Bridges, en el que se establecían de forma definitiva las bases fundamentales de la herencia genotípica
-
En sus investigaciones demostró que las proteínas están compuestas por cadenas de aminoácidos y que la acción de las enzimas es específica, efectuando la hidrólisis de las proteínas complejas en aminoácidos. También desarrolló el modelo de llave-cerradura de las enzimas.
-
Fue el primero en determinar el número de cromosomas humanos en 48, valor que se aceptó como correcto durante más de tres décadas. Descubrió el cromosoma sexual Y o masculino
-
Inició sus investigaciones en el aislamiento de las enzimas en su forma pura, un hecho que nunca se había podido conseguir.Tras encontrarse con muchos fracasos, en 1926 consiguió aislar y cristalizar la enzima ureasa, obtenida a partir de frijoles.
-
Demostró que al tratar células con rayos x se producían mutaciones de forma aleatoria
-
Usó dos cepas de la bacteria Streptococcus pneumoniae: la cepa S (virulenta), que contenía una cápsula de polisacáridos, y la R (no virulenta), que carecía de ella, la cepa R, anteriormente avirulenta, presentaba cápsula y se transformaba en S. Griffith con este experimento hipotetizó que existía un principio transformador
-
Sus investigaciones sobre el virus causante de la enfermedad del mosaico del tabaco le llevaron al descubrimiento y aislamiento de la nucleoproteína que controla su actividad infecciosa.
-
William Thomas Astbury y Florence Bell, al realizar estudios de difracción por rayos X, propusieron que el ADN era una fibra compuesta de bases nitrogenadas apiladas a 0.33 nm unas de otras, perpendiculares al eje de la molécula.
-
Acuñó el término "biología molecular"
-
George Wells Beadle y Edward Lawrie Tatum, encontraron sólidas evidencias de una correlación entre los genes y las enzimas en el hongo Neurospora crassa, mediante el estudio de rutas metabólicas implicadas en la síntesis de los aminoácidos. Sus resultados, publicados en 1941, proponían un vínculo directo entre los genes y las enzimas.
-
Salvador E. Luria y Max Delbrück demostraron que las mutaciones en E. coli ocurrían de forma espontánea, sin necesidad de exposición a agentes mutagénicos, y que éstas se transmitían siguiendo las leyes de la herencia. Estos autores postularon que las mutaciones son las causantes de la resistencia de las bacterias a fármacos
-
Demostraron que las cepas inocuas de neumococo estudiadas por Griffith se transformaban en patógenas al adquirir la molécula de ADN y no proteínas, como se creyó en un principio, y demostraron así que el principio transformante era ADN
-
Descubrió que el ADN (ácido desoxirribonucleico) es el material del que los genes y los cromosomas están formados y de cómo estos definen la sexualidad del ser humano. Anteriormente se creía que las proteínas eran las portadoras de los genes.
-
Oswald Avery, Colin McLeod y Maclyn McCarty trataron de identificar el factor de transformación (FT), que debía encontrarse en los neumococos S muertos por el calor.
-
Chargaff mostró que independientemente del organismo que se tratara (mientras sea ADN de doble helice), la proporción de bases púricas era igual a las de pirimídicas. Por lo tanto, dentro de la molécula, había igual cantidad de Adenina que de Guanina, y por otro lado, igual cantidad de Timina que de Citosina.
-
Lord Alexander Robertus demostró que los nucleótidos se unían al ADN a través de enlaces fosfodiéster, por lo que propuso una estructura lineal para la cadena de ADN
-
Utilizando bacteriófagos (virus que infectan bacterias) marcados con isótopos radiactivos 35S o 32P (el azufre como elemento químico propio de las proteínas y el fósforo del ADN), demostraron que cuando un virus infecta a una bacteria solamente penetra el ADN viral, quedando la cápside viral fuera.
-
El biologo estadounidense James Watson, el fisico y biologo molecular Francis Crick y la quimica inglesa Rosalind Franklin, escribieron la historia, en especial de la genética, al descubrir la estructura helicoidal de la molécula del ADN.
-
Joe Hin Tijo fue un citogenetista indonesio a quien se le considera la primera persona en reconocer correctamente el número normal de cromosomas humanos.
-
Propuso la existencia de la tautomería y la replicación semiconservadora del ADN, y propuso que para la síntesis de proteínas debe existir una molécula mediadora entre las proteínas y el ADN, función que hoy se sabe realiza el ARN
-
En 1955, aislaron una enzima del colibacilo que catalizaba síntesis del ARN. La enzima fue bautizada como polinucleótido fosforilasa, conocido luego como ARN-polimerasa.
En 1959, obtuvieron ARN-polimerasa in Vitro, dando inicio a la carrera para descifrar el código genético -
Francis Crick propuso que el código genético debe leerse en tripletes
-
Confirmaron la replicación semiconservadora propuesta por Crick. En su experimento cultivaron bacterias en un medio que contenía el isótopo 15N (pesado) para marcar las cadenas de ADN progenitoras. Después cambiaron el medio por uno que contenía 14N (ligero) y se permitió que las células se replicaran
-
El científico español Severo Ochoa junto a muchos de sus colegas contemporáneos fueron los descubridores del Código Genético, algunos ayudaron en su determinación, mientras que otros como Ochoa ayudaron a completarlo.
-
Descubrieron los sistemas de restricción de las bacterias
-
De manera independiente descubrieron una nueva enzima denominada transcriptasa inversa o retrotranscriptasa, con función de ADN polimerasa dependiente de ARN.
-
Nathans elaboró el primer mapa de restricción del ADN que detallaba los genes de una molécula de ADN
-
El profesor Rudolf Jaenisch, se convirtió en el pionero de la ciencia transgénica al crear un ratón transgénico, que se convirtió en el primer animal de este tipo en la historia
-
Desarrollaron un método para secuenciar ADN basado en la modificación química del ADN y posterior escisión en bases específicas
-
Fredecrick Sanger, bioquímico ingles, desarrolló el método de secuenciación de ADN, conocido también como método de Sanger. Dos años más tarde empleó esta técnica para secuenciar el genoma del bacteriófago Φ-X174, el primer organismo del que se secuenció totalmente el genoma
-
Un equipo de biólogos norteamericanos utilizaron una cepa de la bacteria conocida como Escherischia coli, que se encuentra comúnmente en el intestino humano, y remodelaron su material genético, añadiéndole un gen sintético en el que se contenía el código de la fabricación de insulina de tipo humano. Así la bacteria fue "inducida" a producir moléculas de insulina y utilizada en cierto modo como una fábrica de esta hormona.
-
Tres avances importantes para la genética se dieron en este año: se efectúa el primer diagnóstico pre-natal de una enfermedad humana por medio del análisis del ADN; se crea el primer ratón transgénico, insertando el gen de la hormona del crecimiento de la rata en óvulos de ratones fecundados y se inventa la técnica PCR, que permite replicar genes específicos con gran rapidez.
-
Desarrolló la PCR, que permite la amplificación de
una secuencia específica de ADN mediante nucleótidos trifosfatados y un ADN polimerasa -
En la década de 1980 se propició el advenimiento de la terapia génica, el uso de genes para el tratamiento de enfermedades. Cuando se llevó a cabo el primer protocolo clínico. El síndrome de inmunodeficiencia combinada grave por déficit de la enzima adenosín deaminasa (ADA) fue la primera enfermedad tratada con terapia génica.
-
Fue el primer mamífero clonado a partir de una célula adulta. Sus creadores fueron los científicos del Instituto Roslin de Edimburgo (Escocia), Ian Wilmut, Keith Campbell. Este fue el mayor logro científico ya que demostró que el ADN de células adultas, a pesar de haberse especializado en un solo tipo de célula, puede usarse para crear un organismo entero.
-
La anemia de Fanconi (AF) es un trastorno hereditario en la reparación del ADN. Este es el caso de la familia Nash en EEUU. Su hija padecía Anemia de Fanconi, y a causa de ello decidieron someter a manipulación genética a su hijo Adam para evitar que este naciera con la enfermedad y a la vez sirviera de "hermano salvador" para su hermana. La técnica utilizada para seleccionar a Adam es conocida como "diagnosis genético de preimplantación" o PGD por sus siglas en inglés
-
Se elaboró y publicó el primer borrador del genoma humano.
-
En abril se publicó la secuencia completa del genoma humano, concluyendo que está constituido por 3000 millones de pares de bases, existen 25000 genes codificantes y que la especie más cercana filogenéticamente al ser humano es el chimpancé.
-
Un grupo de científicos japoneses de la Universidad de Toyama, han publicado un artículo en el Journal of the American Chemical Society en el que describen una clase de C-nucleósidos no naturales (las moléculas del ADN). Estas moléculas, además de ser artificiales, tienen la capacidad de hibridar espontáneamente, lo que configura una estructura molecular estable al calor.
-
Los investigadores construyeron un genoma sintético y lo utilizaron para transformar la identidad de una bacteria. El genoma reemplazó el ADN de la bacteria para que produjera un nuevo grupo de proteínas
-
Se descubrió que el llamado ADN basura es mucho más útil de lo que se pensaba. Y es que, en realidad, éste es esencial para que los genes humanos funcionen ya que regula su actividad
-
El método puede 'editar' los genes cambiando el 'texto genético' del ADN, sin causar ningún tipo de mutación no deseada.
-
Reino Unido autorizara la reproducción asistida que utiliza el ADN de tres personas
-
El déficit del llamado ARN no codificante ultraconservado se relaciona con una mayor propensión a formar tumores.
-
Investigadores del CSIC crean un nuevo método capaz de amplificar ADN a partir del genoma de una sola célula. El procedimiento permitirá amplificar las minúsculas cantidades de ADN que circulan por la sangre para secuenciar ese material genético e identificar mutaciones
-
Los defectos en el llamado “anillo de cohesina”, un complejo de proteínas con forma de anillo, están relacionados con distintos tipos de cáncer. Uno de los aspectos menos conocidos del funcionamiento de este anillo es el mecanismo que permite su apertura y cierre para atrapar y soltar las moléculas de ADN.
-
Un algoritmo que predice la forma de las proteínas a partir de su ADN acelerará la investigación de enfermedades como alzhéimer o diabetes
-
*(s.f.). Obtenido de https://prezi.com/zu88grur_pw6/linea-de-tiempo-de-la-biologia-molecular/
*(s.f.). Obtenido de https://elpais.com/tag/biologia_molecular/a
*Montes, A. S. (s.f.). Biologia molecular. Fundamentos y aplicaciones en las ciencias de la salud. MCGrawHillEducation.
Want to make a timeline like this?
Use Timetoast to turn dates, events, milestones, and phases into a clear visual timeline you can build and share. Timetoast is a timeline maker for work, school, research, and stories.